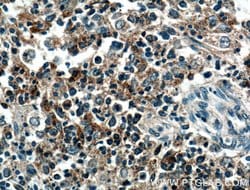
TRAF1 Rabbit anti-Human, Polyclonal, Proteintech:Antibodies:Primary Antibodies
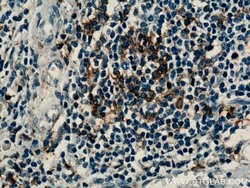
TRAF1 Rabbit anti-Human, Polyclonal, Proteintech:Antibodies:Primary Antibodies

missing translation for 'onlineSavingsMsg'
Learn More
Learn More
TRAF1 Rabbit anti-Human, Polyclonal, Proteintech
Rabbit Polyclonal Antibody
145.00€ - 410.00€
Specifications
| Antigen | TRAF1 |
|---|---|
| Concentration | 0.3 mg/mL |
| Applications | Immunocytochemistry, Immunohistochemistry (Paraffin), Western Blot, Immunofluorescence |
| Classification | Polyclonal |
| Conjugate | Unconjugated |
| Product Code | Brand | Quantity | Price | Quantity & Availability | |||||
|---|---|---|---|---|---|---|---|---|---|
| Product Code | Brand | Quantity | Price | Quantity & Availability | |||||
|
16805195
|
Proteintech
26845-1-AP-20UL |
20 μL |
145.00€
20µL |
Please sign in to purchase this item. Need a web account? Register with us today! | |||||
|
16895185
|
Proteintech
26845-1-AP-150UL |
150 μL |
410.00€
150µL |
Please sign in to purchase this item. Need a web account? Register with us today! | |||||
Description
The protein encoded by this gene is a member of the TNF receptor (TNFR) associated factor (TRAF) protein family. TRAF proteins associate with, and mediate the signal transduction from various receptors of the TNFR superfamily. This protein and TRAF2 form a heterodimeric complex, which is required for TNF-alpha-mediated activation of MAPK8/JNK and NF-kappaB. The protein complex formed by this protein and TRAF2 also interacts with inhibitor-of-apoptosis proteins (IAPs), and thus mediates the anti-apoptotic signals from TNF receptors. The expression of this protein can be induced by Epstein-Barr virus (EBV). EBV infection membrane protein 1 (LMP1) is found to interact with this and other TRAF proteins; this interaction is thought to link LMP1-mediated B lymphocyte transformation to the signal transduction from TNFR family receptors. Three transcript variants encoding two different isoforms have been found for this gene.Specifications
| TRAF1 | |
| Immunocytochemistry, Immunohistochemistry (Paraffin), Western Blot, Immunofluorescence | |
| Unconjugated | |
| Rabbit | |
| Human | |
| Q13077 | |
| 7185 | |
| TRAF1 Fusion Protein Ag25397 | |
| Primary | |
| -20°C | |
| TRAF1 |
| 0.3 mg/mL | |
| Polyclonal | |
| Liquid | |
| RUO | |
| PBS with 50% glycerol and 0.1% sodium azide; pH 7.3 | |
| EBI6, TRAF1 | |
| TRAF1 | |
| IgG | |
| Antigen Affinity Chromatography | |
| Antibody |
Spot an opportunity for improvement?Share a Content Correction
Product Content Correction
Your input is important to us. Please complete this form to provide feedback related to the content on this product.
Product Title